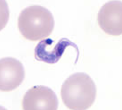

This lecture-style course is taught every fall semester and explores the biology of protozoan and metazoan parasites of medical, veterinary, and socioeconomic significance. Topics for this course include parasite life cycles, pathology, morphology, diagnosis, treatment, and control of parasitic protozoans, platyhelminthes (flukes and tapeworms), nematodes, and arthropods. Upon completion of this course students should:
1. Have obtained an appreciation for the biological complexity of eukaryotic parasites and how they affect human and animal health.
2. Be able to identify major parasite families and their geographical distributions.
3. Understand transmission dynamics and parasite life cycles.
4. Understand the major ecological and behavioral tendencies that foster parasite persistence.
5. Understand how parasites affect the social and economic development of human populations worldwide.
6. Understand the importance of arthropods as vectors of disease.
BSCI 3236 - Parasitology

This discussion-style course was taught between 2008 and 2015. The course is divided into instructor-led lectures/discussions and student presentations that tackle both broad topics and recent articles from the primary scientific literature. The overall objectives of the course are to:
1. Explore the interactions between viral, bacterial, and parasitic pathogens and their hosts, including mechanisms of transmission, immune evasion, and the role of multiple hosts in life cycle perpetuation.
2. Examine the effect of drug resistance, travel, conflict, and climate/environmental change on the spread of infectious diseases.
3. Explore how infectious diseases affect the social and economic development of entire human populations.
4. Provide students with experience reading, presenting, and critically evaluating scientific literature.




BSCI 3965 - Epidemiology and control of infectious diseases
Extensive research opportunities are available for undergraduate students in the Hillyer Lab. Students initially spend a semester learning about mosquito immunology and physiology (BSCI 3860) before beginning a directed research project (BSCI 3861). Following completion of BSCI 3861 students are expected to achieve a higher level of independence in research (BSCI 3961) before enrolling in the Biological Sciences Honors Research Program (BSCI 4999).
Undergraduate students in my lab have used their research projects to graduate with honors, publish articles in peer-reviewed scientific journals, and earn research fellowships and awards. Following graduation, undergraduates in the Hillyer lab have gone on to graduate school, medical school and veterinary school. For more information see the Hillyer Lab “undergraduate research” webpage.
BSCI 3860 - Introduction to research
BSCI 3861 - Directed laboratory research
BSCI 3961 - Independent laboratory research
BSCI 4999 - Honors research

BSCI 1511 - Introduction to Biological Sciences
This lecture-style course is offered every spring and represents the second semester of introductory biology for majors. The course introduces the students to the fields of (1) cell communication, (2) development, (3) physiology, (4) genetics, (5) evolution, and (6) ecology. This course is designed in a manner that fosters the development of critical thinking in biological sciences. Dr. Hillyer teaches the first three topics.



